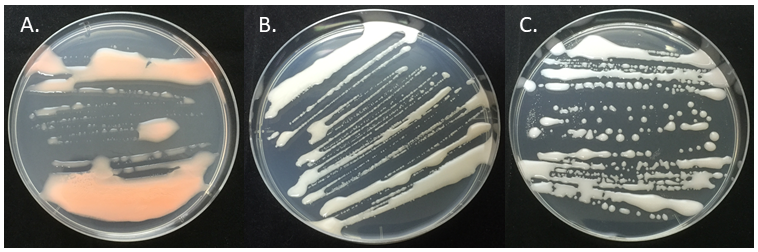

【トピックス】
南極に生息している菌類とその産業への利用に向けて
辻 雅晴
旭川高専・物化
1.はじめに
みなさんは南極大陸と聞くと、雪や氷に閉ざされた大地とか無生物の環境などをきっと思い浮かべるだろう。南極大陸は、-90℃以下という観測至上最低気温を記録したこともある極度の低温と乾燥に晒された地球上で最も過酷な環境の1つである。しかし、雪と氷に覆われた大地だけかというとこれは少し違う。南極大陸の約98%は雪や氷に覆われているが、残りの2%は沿岸部や高山などに分布し、夏になると雪が溶けて地面が露出する露岩域となる。南極大陸の陸上生態系のほとんどはこの露岩域に分布しており、南極大陸は無生物ではない。日本の南極観測の拠点である昭和基地周辺も夏になると地面が露出する露岩域となっている。南極大陸には陸上哺乳類は生息しておらず、昭和基地周辺では生態系の頂点はセンチュウ、ワムシ、クマムシとなっており、みなさんが想像している生態系とは少し異なるかもしれない。
このように世界で最も過酷な環境の1つである南極域だが、これまでに1000種以上の菌類が報告され、そのうち約300種は南極域の中でも特に環境が厳しい大陸性南極から見つかっている1)。これらの菌類はその低温に特化した特徴から、近年新たな微生物資源としても注目を集めている。本稿では、日本の南極観測の歴史、南極に生息している菌類について概説し、これらの菌類の産業利用を目指す筆者の取り組みと将来構想をご紹介したい。
1-1 日本の南極観測の歴史
日本の南極探検は、1910年~1912年にかけ南極点を目指した白瀬矗 (しらせのぶ、1861年~1946年) が大和雪原 (やまとゆきはら、南緯80度、西経156度) に到達したのが始まりだ。戦後、1955年に日本学術会議会長から内閣総理大臣宛に国際地球観測年における南極地域観測への参加について要望書が提出され、「南極地域観測への参加および南極地域観測統合推進本部の設置について」として閣議決定されたことから、1956年に第1次南極地域観測隊が永田武博士 (当時、東京大学、1913年~1991年) を隊長として現在の昭和基地に派遣されることとなった。南極観測は1962年~1964年の一時中断を経て、1965年からは毎年観測隊が派遣されている2)。実は日本で南極観測が行われている根拠はこの閣議決定だけあり、国としての基本政策は存在しない。一方、南極の対極にある北極観測は「我が国の北極政策」 (2015年) という基本政策があり、この政策を根拠として研究が実施されている。国立極地研究所は1973年に国立科学博物館から独立する形で設置され、現在まで日本の南極観測や北極観測の中心的な役割を担ってきている。日本の南極地域観測隊には、第48次観測隊 (2006年~2007年) に参加した星野保博士 (当時、産業技術総合研究所;現在、八戸工業大学) と第51次観測隊に参加した大園享司博士 (当時、京都大学;現在、同志社大学) の2名だけが菌学者として参加している。
2.南極に住む氷点下でも成長する菌類
昭和基地周辺から分離した菌類については、1961年に椿啓介博士 (当時、発酵研究所、1924年~2005年) が報告したのが始まりで、1965年までの4年間で4本の論文を発表し、子のう菌類12種、担子菌類4種を報告している3-6)。その後、昭和基地周辺の菌類については、筆者が2013年に報告するまで約50年間報告はなかった。筆者らは、南極の昭和基地周辺の2地点 (昭和基地がある東オングル島とそこから約60 km離れたスカルブスネス露岩域) における菌類の多様性調査を行った。その結果、東オングル島ではVishniacozyma属、Naganishia属、Cystobasidium属などの担子菌酵母が優占していた7)のに対し、スカルブスネス露岩域ではMrakia属、Cryptococcus属などの担子菌酵母、Thelabolus属などの子のう菌類が優占していた8)。南極大陸では、環境が厳しくなるにつれ、担子菌類の中でも単細胞の菌類である担子菌酵母の占める割合が増える。両地域でも担子菌酵母が優占していることは共通していたが、出現する菌種は全く異なっていた。この菌類調査の中で、筆者らは幸運にもCystobasidium tubakiii (C. tubakiiは椿啓介先生のお名前から付けさせていただいた)とC. ongulenseという2種の新種の菌類を日本の南極観測史上初めて報告することができた9)。これらの研究の成果もあり、2013年から2019年までの7年間で昭和基地周辺から報告した菌類の種数は16種から77種と約4.8倍まで増加した10)。これは大陸性南極から報告されている菌類の約1/4を占めており、日本の研究チームは南極産菌類の分野で世界トップクラスの成果を残している。
昭和基地における冬季の気温は-40℃前後で、これは筆者が現在住んでいる北海道旭川市の最低気温とあまり変わらない。しかし夏季には30℃以上になる北海道とは異なり、南極の昭和基地では1年のうち10ヶ月間は平均最高気温がマイナスとなっている。つまり、昭和基地では1年の大半を0℃以下の気温となる。では、南極に生息している菌類は氷点下でも成長するのだろうか?筆者は昭和基地のある東オングル島から分離した生育上限温度が15℃以下の好冷菌から30℃まで成長が可能な耐冷菌までの16種を選抜し、-3℃で培養することで氷点下における成長能を調べてみた。-3℃という培養温度は、インキュベータなどの温度の誤差を考慮すると、菌類の培養実験で広く使われているYPD液体培地やポテト・デキストロース寒天培地が凍らない下限の温度である。その結果、至適増殖温度や増殖上限温度に関わらず、全ての種で-3℃での増殖を確認した7)。実際に-3℃で3週間培養した際のシャーレの写真が図1である。3週間の培養で、はっきりとコロニーが確認できるまで増殖しているのが分かる。

南極産菌類が-3℃で成長が可能ということは、つまりこれらの菌類は氷点下でも活性のある酵素を持っているということになる。現在、筆者は南極産菌類が持つ氷点下でも活性のある酵素が産業利用できる可能性があると考え、リパーゼやβ-ガラクトシダーゼ、ゼルラーゼなど様々な酵素の探索を行っている。
3.南極産菌類による酪農排水処理
ここでは、南極産菌類を利用した酪農排水処理について紹介したい。
乳牛の搾乳室から排出される酪農排水は、大量の乳脂肪を含んでいる。北海道のような酪農が盛んな地域では、冬季の水温の低下によって乳脂肪が凝固し、微生物による分解が困難である。そのため、乳脂肪を大量に含む酪農排水は微生物による浄化処理が十分に処理されないまま野外に放出され、海などの汚染の原因となっており、漁業、特に鮭鱒の産卵への悪影響が懸念されている。この問題を解決するため、筆者らは地球上で最も寒い南極に生息している菌類の中から、低温で高い乳脂肪分解能を持つ菌のスクリーニングを行った。昭和基地周辺から分離した75株の菌類について生クリームを含んだ寒天培地で4℃と10℃で培養したところ、56株でコロニーの周りに生クリームが分解してできるクリアーゾーンが形成され、その全てが担子菌酵母のMrakia属菌だった11)。低温で乳脂肪分解能を持つ56株のうち、Mrakiablollopis SK-4株が4℃で最も高い乳脂肪分解能を持っていたことから、SK-4株を利用しての酪農排水処理実験を行うこととした。
実際に北海道の酪農施設で利用されている活性汚泥 (通常の活性汚泥) と、通常の活性汚泥にSK-4株を添加した活性汚泥 (SK-4株入り活性汚泥) を10℃のバッチ式 (1つの槽内で、汚水投入、ばっ気、沈殿、処理水の排出を行う方法) でモデル酪農排水 (牛乳を基質として使用) の処理を24時間行った。その結果、SK-4株入り活性汚泥では、通常の活性汚泥と比べて乳脂肪除去率が約25%向上することが確認された12)。北海道東部の酪農排水は厳冬期で約3~4℃、盛夏期で20℃~25℃であるため、水温を3℃~25℃で変化させ30週間の連続処理実験を行った。SK-4株を25℃で11週間連続処理すると、SK-4株は初期菌数の約10%まで減少するが、死滅することはなく、水温を3℃に低下させることで再び増殖することが確認された (図2)13)。また、水温が3℃でも乳脂肪除去率は80%以上を維持したことから、SK-4株を利用した酪農排水処理システムは、北海道のような寒冷地で実用化できることが示された。これらの研究成果の一部は特許第5867954号「乳脂肪分解能を有する南極産担子菌酵母およびその利用方法」として登録され、現在、民間企業がこの特許技術を利用した排水処理システムを商品として販売している。この商品は南極観測によって分離された微生物を使用した国内で初めての例であり、今後、寒冷地における生活排水や工業排水の処理、さらに南極の昭和基地での排水処理への利用も可能と期待している。


4.おわりに-南極産菌類の産業利用を目指して-
南極産菌類が持つ氷点下での成長能や氷点下でも活性のある酵素などの特徴は、低温でのバイオプロセスや食品加工などへの利用が期待できることから、微生物資源としても注目を集めている。しかし、残念ながら現在までに日本で昭和基地周辺から分離された菌類を含む南極産微生物を産業利用した例は、本稿で紹介した酪農排水処理への利用の1件のみである。
筆者は、南極産菌類が産業利用されない原因の1つに、菌株へのアクセスの困難さがあると考えている。皆さんは南極の微生物に興味があり、基礎研究や研究開発に使用してみたいと思った時、どうするだろうか?恐らく多くの人は、日本の菌株保存機関である理化学研究所のJCMや製品評価技術基盤機構 (NITE) のNBRCのカタログを探すだろう。しかし、JCMやNBRCに寄託されている昭和基地周辺から分離された菌類は、筆者が調べた限りでは、77種のうちわずか5種8株のみとなっている。どうやら日本では研究者個人が南極産菌類の管理をしており、研究者の移動や退職によって、これまで分離された貴重な菌株の多くが廃棄されているようだ。このように、南極産菌類は微生物資源として注目を集めながらも、日本では菌株保存機関にほとんど保存されていないことから、多くの研究者や企業が南極産菌類にアクセスすることが困難であり、このままでは貴重な南極産菌類が産業利用されずに日本から失われてしまう可能性がある。
そこで筆者は、南極産菌類の菌株を長期的に保存することで、貴重な菌株の散逸を防ぐと共に、これらを広く公開することで研究者や企業がアクセスし易くしたい。しかし、菌株が保存され公開されているだけでは、企業がすぐに産業利用することは難しい。そこで、菌株の保存すると同時に、基礎研究と企業の研究開発のギャップを埋めるという2つの機能を持った研究センターを大学か研究所にできるだけ早く設置したい。研究者の定年や異動によって研究内容が変わる研究室よりも、長期的な視点により菌株の保存や研究を継続できる研究センターの方が適している。研究センターは将来的にナショナルバイオリソースプロジェクトの中核機関を目指す。南極産菌類を保存し、その低温での類まれな能力を広く研究者や民間企業に利用してもらう事で、日本で南極産菌類の産業利用という新しい研究分野を確立することができる。バイオ分野でイノベーションを起こし、日本がこの分野で世界をリードするようになるだろう。南極産菌類の研究センターの実現に向けて、ぜひ皆さんのご支援をお願いしたい。
文献
1) Bridge, P. D., Spooner, B. M.: Fungal Ecol., 5, 381 (2012).
2) 神沼克伊: 日本地球惑星科学連合ニュースレター, 3, 1 (2007).
3) Tubaki, K.: Biol Results JARE, 14, 1 (1961).
4) Tubaki, K.: Antarctic Record (Tokyo), 11, 161 (1961).
5) Soneda, M.: Biol. Res. Jpn. Res. Expedition, 15, 3 (1961).
6) Tubaki, K., Asano, I.: JARE scientific reports. Ser. E, Biology, 27, 1 (1965).
7) Tsuji, M.: Polar Biol., 41, 249 (2018).
8) Tsuji, M., Fujiu, S., Xiao, N., Hanada, Y., Kudoh, S., Kondo, H., Tsuda, S., Hoshino, T.: FEMS Microbiol. Lett., 346, 121 (2013).
9) Tsuji, M., Tsujimoto, M., Imura, S.: Mycoscience, 58, 103 (2013).
10) Tsuji, M.: Mycoscience, 59, 319 (2018).
11) Tsuji, M., Yokota, Y., Kudoh, S., Hoshino, T.: Cryobiology, 70, 293 (2015).
12) Tsuji, M., Yokota, Y., Shimohara, K., Kudoh, S., Hoshino, T.: PLOS ONE, 8, e59376 (2013).
13) Tsuji, M., Kudoh, S., Hoshino, T.: Fungi in Polar Regions, 1, 120 (2019).